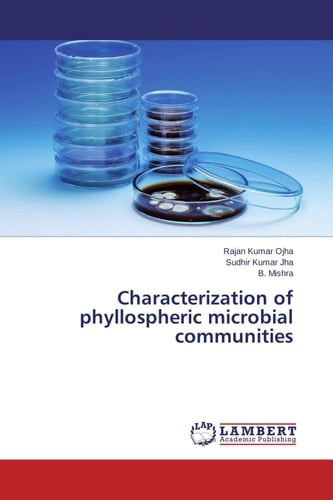
Characterization of Phyllospheric Microbial Communities

This book discuss about principles and techniques of isolation, characterization & identification of phyllospheric micro-organism. Effect of pollutants on micro-organisms was also been discussed in the book. Attempt has been made to identify specific properties of micro-organisms such as N-fixation, Phosphate solubilization & cellulose decomposition and test their efficiency in laboratory & field condition. This book is useful for students, researchers and scientists, who are interested in deeper study in phyllospheric microbial community.
Page Count:
156
Publication Date:
2014-01-01
ISBN-10:
3659464198
ISBN-13:
9783659464195
No comments yet. Be the first to share your thoughts!